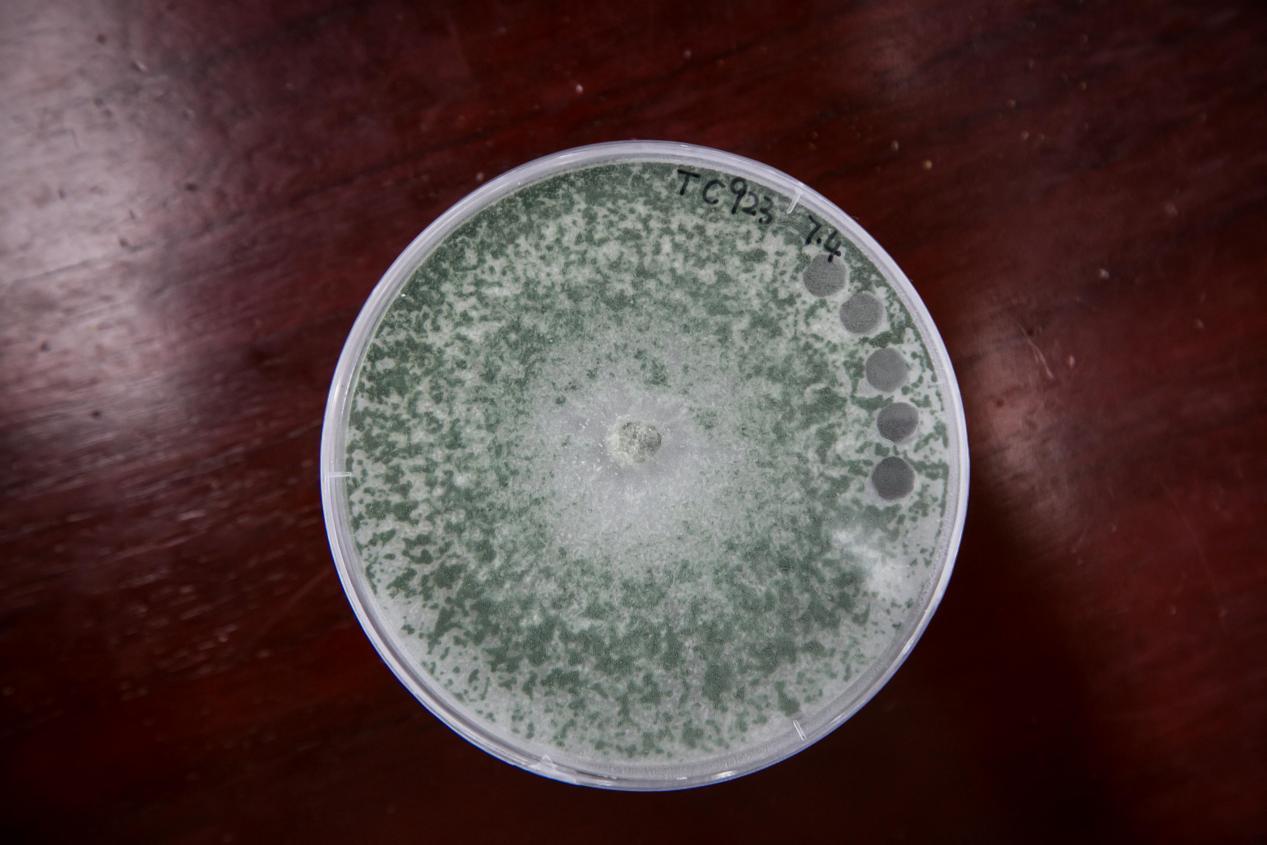

2021年北京“最美科技工作者”|庄文颖:真菌世界的“大先生
2021-12-15
作者:佚名
来源:科普中国
今年,北京首次遴选“最美科技工作者”,真菌学家、中科院院士庄文颖当选。今天就让我们走近她,一起探寻真菌世界的有趣故事。
【编者按】为进一步弘扬科学家精神,激发广大科技工作者的荣誉感、自豪感、责任感,中共北京市委宣传部、北京市科学技术协会、北京市科学技术委员会、中关村科技园区管理委员会、北京市经济和信息化局首次联合开展2021年北京“最美科技工作者”学习宣传活动,经过广泛发动、层层推荐、资格审核、专家遴选等程序,庄文颖等10名同志当选2021年北京“最美科技工作者”。数十年来,她沉浸在自己的研究天地中,面对繁华多姿的世界心如止水;她在自己的领域中不断摸索,将真菌领域中一个个未知物种揭开面纱;她给它们分类或者命名,赋予它们在真菌世界中的准确坐标。
她就是中国科学院院士、中国科学院微生物研究所研究员庄文颖。2009年当选为中国科学院院士后不久,她又相继当选为第三世界科学院院士、欧亚科学院院士。在真菌学领域,她已经成了功勋卓著的“庄先生”“大先生”。
在这浩瀚的未知领域里,庄文颖倾尽近50年的光阴,夙兴夜寐,潜心研究。作为中国真菌学的引领者之一,她在这个领域里深耕开拓,作出了举世瞩目的贡献。
日前,北京市委宣传部、北京市科协等部门首次联合开展北京最美科技工作者学习宣传活动,庄文颖被遴选为2021年北京“最美科技工作者”。

▲庄文颖被遴选为2021年北京“最美科技工作者”
与真菌结缘
庄文颖院士1948年出生于北京,原籍福建省闽侯县,她几乎是与共和国一道成长、发展的一代人。上世纪60年代,庄文颖同广大知识青年一起,响应国家号召下乡务农,在基层劳动的时候,她依旧利用空闲时间见缝插针地努力学习文化知识。1973年,当进入山西农学院(现山西农业大学)学习的宝贵机会降临时,她因长期的准备得到命运的垂青。顺利入学后,在昆虫学和植物病理学两个可以选择的方向中,庄文颖选择了后者,由此走进了真菌的世界。
早年的下乡务农经历为庄文颖之后的职业选择埋下了伏笔。在劳作过程中,她注意到小麦等一些农作物的病害是与产量相关的一个不可忽视的因素,严重的病害常常会导致粮食大量减产,而真菌感染常常是最主要的病因。为了搞清植物病原真菌的致病原理,她开始对研究真菌有了兴趣,最终选择走上了这条科研道路。

▲中科院微生物所菌物标本馆里收藏的链格孢(水稻穗腐病)标本
在这条求知的路上,庄文颖越来越不满足。为了能继续深造,她努力自学,在1978年考取了恢复高考后的第一届中国科学院研究生院硕士研究生,师从真菌学家余永年先生。为了尽快在真菌学研究中走向国际前沿,1983年已经是中国科学院微生物研究所助理研究员的庄文颖又作为访问学者,前往美国康奈尔大学交流学习。1985年,庄文颖又到康奈尔大学攻读真菌学博士学位。

▲庄文颖院士在实验室
在美国留学时,庄文颖比同学的年龄要大很多,年龄是她从事研究的劣势,因此,她比别人更加努力。别人学习时,她在潜心研究;别人休息时,她在潜心研究;别人休闲玩耍时,她还在潜心研究。“我要把当年耽误了的宝贵学习时光都追回来。”就这样,她一步步走上了真菌学领域的国际前沿。
1987年博士毕业后,庄文颖毫不犹豫地回到更需要她的祖国。她的想法是,中国地域广阔,真菌种类极其丰富,并且绝大部分都还无人问津,没有人曾研究过它们,但是这些必须要有人来做,这对她来说是更加广阔的研究舞台。
心甘情愿当垫脚石
真菌领域是一个种类繁多、充满未知的世界,让更多的真菌被发现、被描述,被庄文颖视为己任。“我主要是做分类,就是说野外拿回真菌标本或者样品以后,我首先要知道它是什么,进行归类,然后探讨它是不是有理论或者应用研究的价值,我工作的侧重点在分类学部分。”
回国以后,庄文颖迅速投入到子囊菌部分类群的资源、分类、DNA条形码、分子系统学等方面的综合研究。她始终秉持严肃求实的科学精神,不盲从权威,不迷信教条。以前分类不明的,她予以明晰化。存在分类错误的,她带领团队经过精心的研究,对其分类予以更正。
分类学是一项基础性的研究工作,绝大多数工作都是在为他人做嫁衣裳。有了科学和系统的分类,其他研究人员进行有关菌物的深入研究才会更加方便。既然选择了这个研究领域,庄文颖心甘情愿担当这样的垫脚石。“这样的工作总是需要人来做的。”她说。

▲日前,在北京广播电视台举办的2021年“北京市最美科技工作者”学习宣传活动上,庄文颖院士(左)与助手展示炫彩斑斓的真菌世界。助手身穿的T恤衫上印有中科院微生物所发现的真菌物种。
从事分类学研究,野外科考工作是必不可少的。早些年,庄文颖和同事们深入我国广大林区、荒漠、高原等艰苦地区开展第一手真菌资源调查,努力探索我国真菌资源的家底。他们的重要任务是首先把各种各样的真菌标本采集回来。不同类型的真菌差异很大,大个头的蘑菇较为醒目,在野外只要在合适的时间找对生境(生物的个体、种群或群落所在的具体地域环境),发现和采集相对容易,但是有一些微小的真菌,靠肉眼根本发现不了,需要用放大10倍的放大镜,趴在地上一寸一寸地搜寻。趴得时间长了,人就很难受。很多微小的真菌只有在特别潮湿的地方才有,在这样的环境中寻找小型真菌就会更加艰苦。
进行真菌的采集,越是人迹罕至的地方往往收获越大。云雾缭绕的原始森林、荒无人烟的大漠戈壁,都留下了庄文颖和同事们的足迹。“很多时间都要花在路上。由于当时条件所限,舍不得花钱寄回标本,我们拿竹竿抬着纸箱里边的标本前行,越走越重,最后将采集的材料抬回北京。”庄文颖回忆说。

▲炫彩斑斓的真菌世界(供图/中科院微生物所)
这种求实攀登的精神,使得庄文颖完成了子囊菌3个属的世界性研究,建立正确的物种概念,完善了现行的分类系统;澄清了真菌领域大量分类学和命名问题,为推动学科建设与发展作出了奉献。她带领团队开展中国区域性菌物资源与分类、物种多样性、分子系统学、数据库建设等方面的综合研究,为掌握我国真菌资源的总体情况作出了突出贡献,为真菌资源储备和利用奠定了坚实的物质基础。

▲2017年,庄文颖院士团队发现肉座菌目一新科(供图/中科院微生物所)
庄文颖也是首位参与编写国际真菌学领域权威工具书《真菌辞典》的中国籍学者。鉴于她在国内外被公认的学术贡献,学者们以她的名字命名了一个真菌新属文颖盘菌属(Wenyingia)和一个细菌新属海庄文颖氏菌属(Wenyingzhuangia)。
推动真菌的基础研究成果走向应用
在很长的时间里,庄文颖的主要精力都是放在真菌的基础研究上,在应用方面建树并不多。近些年,她将越来越多的精力放在推动真菌资源的利用上。
真菌与人类的关系极为密切,除了可以直接食用的大型蘑菇,人类很早就学会了利用酵母菌来酿酒、蒸馒头。上世纪20年代,英国细菌学家弗莱明从青霉菌中发现的青霉素,被投入应用以后将人类的平均寿命从40岁提高到了60岁,带来了划时代的意义。后来发现的头孢菌素、灰黄霉素等药物都是源自于真菌,真菌的世界里肯定还有很多等待开发的具有重大药用价值的种类。

▲我国的部分常见药用真菌。图片来源于网络。
庄文颖表示,总体而言动物和植物都比较宏观,所以研究的历史就相对比较长一点,而真菌绝大多数比较微观,有时候一把土里面就有不计其数的真菌,但大家都看不到摸不着,不易引起人们的注意,因此研究起步较晚,研究历史相对来讲就比较短。
真菌是与动物和植物并称的一大类真核生物,是保护生态文明、保障国民生命健康、保持国家经济发展和保卫国门生物安全的重要战略资源。据保守估计,全球约有220万-380万种真菌,有专家估计我们国家的真菌大概有150万-300万种。
“实际上我们已经发现并命名的真菌也就约6%,剩下94%也是有潜在价值的生物资源,这里面很多真菌都是可以培养的,通过培养我们可以做许多事情。”她说。
这些年,木霉成了庄文颖重点关注的对象。她说木霉属真菌部分种类具有很强的降解纤维素能力,针对多年来困扰环境保护和农业生产的秸秆还田问题,她带领团队利用多年来积累的菌株,开展木霉降解秸秆能力评价的研究。
▲庄文颖院士团队收集并研究的木霉菌株,学名Chloroplenium chlora(Schwein.)M.A.Curis 。在腐木上生长,采集于河南龙峪湾。
“我国东北黑土地中秸秆还田可以恢复或者保持土壤肥力,但是东北比较冷,温度不够时真菌发挥分解作用就有一定的难度,木霉将来可能会成为一种理想的选择。二战的时候,美军的帐篷就被一种真菌给‘吃’掉了,帐篷都腐败了,后来的研究表明是木霉降解了帐篷布里的纤维素。所以我们想,如果要做秸秆还田,可以让木霉也发挥这种作用,因为秸秆也是纤维素,它如果能够腐蚀帐篷,它也应该在某种程度上可以腐蚀和分解秸秆。”庄文颖和她的团队正在探索不同木霉菌株的最适作用条件,希望筛选出具有应用潜力的菌株,尽早推动木霉在秸秆还田中发挥作用。

▲降解纤维素木霉菌株初筛。(供图/中科院微生物所)
我国是食用菌大国,占世界总产量50%以上。同时,我国也是利用真菌最早的国家之一,在食品、医药、酿造等方面很早就有记载。真菌中食用菌的开发带动一些地方脱贫致富。目前已经被成功开发并规模化种植的食用菌种类还十分有限,这里面的前景非常广阔。
尽管现在庄文颖已经73岁,但依旧带着她的科研团队在真菌学研究的广阔海洋中探索,希望通过自己的努力,让中国的真菌学研究能够引领国际潮流,也让中国数量庞大的真菌资源不断走向应用市场,将来能够爆发出更大的经济能量。
把科学研究的精神传递给下一代
跟随庄文颖做研究的中国科学院微生物研究所高级工程师郑焕娣说,加入团队十多年以来,庄先生严谨治学、实事求是的科学态度深深地影响着自己以及身边的其他科研人员和学生。
这或许与庄文颖的父亲和导师有关,她的父亲也是中国科学院院士,父女二人成就了“一门两院士”的传奇与佳话。尽管他们从事的研究领域不同,严谨治学的学风在两代人中得到传承。而对庄文颖影响深远的另一个人,就是她的硕士研究生导师余永年。余永年2014年以91岁的高龄辞世,他一生主要从事菌物学科研、教学和著述,成就颇丰,在菌物系统学、生态学、生理学和发展史等多个领域都作出了突出贡献,他的教导也让庄文颖能够站在巨人的肩上迎来了自己的人生飞跃。
熟悉庄文颖的人都知道,她办公室的窗台上一直放着一个老式暖水壶,这个铁皮暖水壶是她导师曾经使用的,从1993年至今她一直在用。有人问她为什么不换一个新的,她说,“还可以用。我每天用它喝水,就会想起我的导师,想起他对我的教育和培养,他不是院士,却是我心目中永远的院士。”

▲庄巧生(左)和庄文颖(右)(供图/中科院微生物所)
郑焕娣告诉记者,庄先生极其严谨,在修改青年科研人员和学生撰写的论文时,除了文章内容外,诸如标点符号、字体、空格等不易发现的细节,她也会逐一标注并予以订正。也正是这种严谨治学态度的传递,庄文颖院士在真菌分类学研究领域培养出了一批能够独当一面的年轻人。
近些年,庄文颖也积极致力于提高全民科学素质,努力为科学普及工作尽己所能。她不仅参与编写和审核了第三版《中国大百科全书》,也多次到中小学课堂上进行科普知识传播,并在“首都科学讲堂”等公众平台授课。
庄文颖说,真菌的世界还藏着无数的秘密和宝藏,让更多的青少年了解真菌,将来从事真菌领域的有关研究,也是她的重要责任和使命。
撰文/记者 李鹏 摄影/张星海(除署名外)
图文编辑/陈永杰 新媒体编辑/吕冰心

出品:科普中央厨房
监制:北京科技报 | 科学加客户端
欢迎分享到朋友圈
来源: 科学加
(责任编辑:王翔)
声明:文章版权归原作者所有,本文摘编仅作学习交流,非商业用途,所有文章都会注明来源,如有异议,请联系我们快速处理或删除,谢谢支持。
(原文章信息:标题:,作者:佚名,来源:科普中国,来源地址:https://cloud.kepuchina.cn/newSearch/imgText?id=6826719035577061376)
友情链接

佰里服务-公众号
扫码关注随时看








